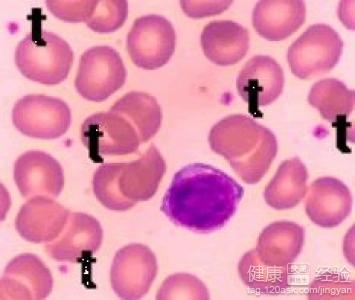
關於嬰兒血小板增高，是怎麼辦

關於嬰兒血小板增高,是怎麼辦
概 述
嬰兒血小板增高症是目前讓很多父母十分頭疼的事情,由於血小板增高症誘發因素多樣,因此,血小板增高症並不是一個十分容易避免的病症,一般來講,手術、外傷以及日常生活中常見的風濕病、關節炎等藥物服用後的反應也會引起血小板增高現象,因此,嬰兒血小板增高症是需要家長刻不容緩對患兒進行治療的病症,那麼,嬰兒血小板增高應該怎麼辦呢?
步驟/方法:
1一般來講,嬰兒血小板增高症的治療目的是讓嬰兒自身的血小板減少或者向正常值靠攏,因此,服用藥物是很多血小板增高症患者最常選用的治療方法,骨髓抑制性藥物是最常使用的血小板增高症診治方法,但由於嬰兒自身免疫力不高,因此嬰兒不宜食用過多藥物。

2血小板分離術是治療嬰兒血小板增高症治療十分常見的手術方式,血小板分離術能夠遜色減少血小板的數量,從而對嬰兒血小板增高症的症狀有所減緩,不過其最佳效果適用於一些類似於胃腸道出血及分娩等一些選擇性手術前進行。
3干擾素是目前醫療行業最新興起的治療血小板增高症的一種手術方式,其可以成功的抑制血小板生存期限,從而降低血小板的數量,除此之外,消炎止痛以及阿司匹林等藥物也對血小板增高症的治療有一定的治療效果。
注意事項:
嬰兒血小板增高症是目前十分常見的一種小兒疾病,家長在發現小兒身體不適症狀時,一定要及時帶小兒進行就醫,以免耽誤時機加重病情。
- 上一頁:寶寶各階段如何正確喂養
- 下一頁:嬰兒用紙尿褲是導致紅臀最主要的原因嗎
- 關於0到1歲知識
-
輕松學會給新生寶寶的皮膚護理。
概 述 很多的年輕媽媽在剛剛做媽媽的時候
-
推薦寶寶周歲內最喜愛的玩具
寶寶從生下來開始,家長們就開始給寶寶准備各種玩具,
-
治療寶寶消化不良的食療方
消化不良,是寶寶常見病之一,寶寶腸道蠕動功能失常或消化酶分泌量
-
驚厥的症狀





